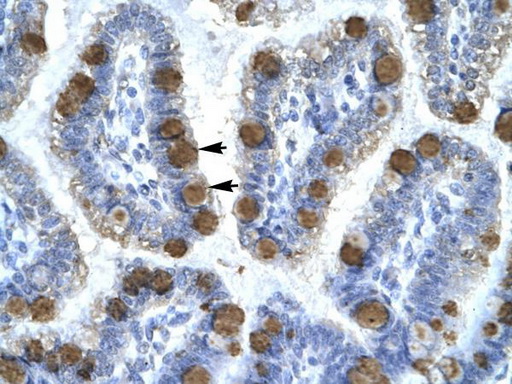

CDK7 Rabbit Polyclonal Antibody
Other products for "CDK7"
Specifications
| Product Data | |
| Applications | IHC, WB |
| Recommended Dilution | WB, IHC |
| Reactivities | Human |
| Host | Rabbit |
| Isotype | IgG |
| Clonality | Polyclonal |
| Immunogen | The immunogen for anti-CDK7 antibody: synthetic peptide directed towards the C terminal of human CDK7. Synthetic peptide located within the following region: NRPGPTPGCQLPRPNCPVETLKEQSNPALAIKRKRTEALEQGGLPKKLIF |
| Formulation | Liquid. Purified antibody supplied in 1x PBS buffer with 0.09% (w/v) sodium azide and 2% sucrose. Note that this product is shipped as lyophilized powder to China customers. |
| Conjugation | Unconjugated |
| Storage | Store at -20°C as received. |
| Stability | Stable for 12 months from date of receipt. |
| Predicted Protein Size | 39 kDa |
| Gene Name | cyclin-dependent kinase 7 |
| Database Link | |
| Background | The protein encoded by this gene is a member of the cyclin-dependent protein kinase (CDK) family. CDK family members are highly similar to the gene products of Saccharomyces cerevisiae cdc28, and Schizosaccharomyces pombe cdc2, and are known to be important regulators of cell cycle progression. This protein forms a trimeric complex with cyclin H and MAT1, which functions as a Cdk-activating kinase (CAK). It is an essential component of the transcription factor TFIIH, that is involved in transcription initiation and DNA repair. This protein is thought to serve as a direct link between the regulation of transcription and the cell cycle. [provided by RefSeq, Jul 2008] |
| Synonyms | CAK1; CDKN7; HCAK; MO15; p39MO15; STK1 |
| Note | Immunogen sequence homology: Bovine: 100%; Horse: 100%; Human: 100%; Pig: 100%; Dog: 94%; Guinea pig: 94%; Mouse: 88%; Rat: 88% |
| Reference Data | |
| Protein Families | Druggable Genome, Protein Kinase, Stem cell - Pluripotency, Transcription Factors |
| Protein Pathways | Cell cycle, Nucleotide excision repair |
Documents
| Product Manuals |
| FAQs |
{0} Product Review(s)
0 Product Review(s)
Submit review
Be the first one to submit a review
Product Citations
*Delivery time may vary from web posted schedule. Occasional delays may occur due to unforeseen
complexities in the preparation of your product. International customers may expect an additional 1-2 weeks
in shipping.






























































































































































































































































 Germany
Germany
 Japan
Japan
 United Kingdom
United Kingdom
 China
China